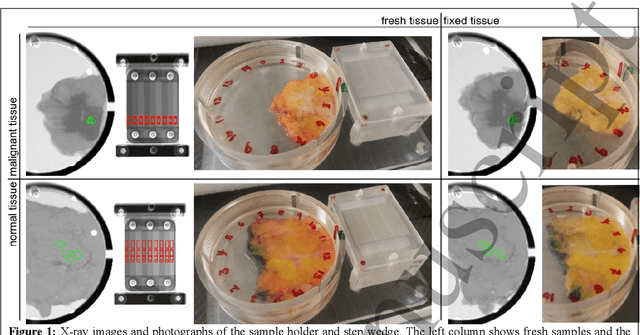
Figure 1 for Measurement of breast-tissue x-ray attenuation by spectral imaging: fresh and fixed normal and malignant tissue

Matthew G. Wallis
Measurement of breast-tissue x-ray attenuation by spectral mammography: first results on cyst fluid
Jan 07, 2021



Abstract:Knowledge of x-ray attenuation is essential for developing and evaluating x-ray imaging technologies. For instance, techniques to better characterize cysts at mammography screening would be highly desirable to reduce recalls, but the development is hampered by the lack of attenuation data for cysts. We have developed a method to measure x-ray attenuation of tissue samples using a prototype photon-counting spectral mammography unit. The method was applied to measure the attenuation of 50 samples of breast cyst fluid and 50 samples of water. Spectral (energy-resolved) images of the samples were acquired and the image signal was mapped to equivalent thicknesses of two known reference materials, which can be used to derive the x-ray attenuation as a function of energy. The attenuation of cyst fluid was found to be significantly different from water. There was a relatively large natural spread between different samples of cyst fluid, whereas the homogeneity of each individual sample was found to be good; the variation within samples did not reach above the quantum noise floor. The spectral method proved stable between several measurements on the same sample. Further, chemical analysis and elemental attenuation calculation were used to validate the spectral measurement on a subset of the samples. The two methods agreed within the precision of the elemental attenuation calculation over the mammographic energy range.
* arXiv admin note: substantial text overlap with arXiv:2101.02449
Measurement of breast-tissue x-ray attenuation by spectral imaging: fresh and fixed normal and malignant tissue
Jan 07, 2021



Abstract:Knowledge of x-ray attenuation is essential for developing and evaluating x-ray imaging technologies. In mammography, measurement of breast density, dose estimation, and differentiation between cysts and solid tumours are example applications requiring accurate data on tissue attenuation. Published attenuation data are, however, sparse and cover a relatively wide range. To supplement available data we have previously measured the attenuation of cyst fluid and solid lesions using photon-counting spectral mammography. The present study aims to measure the attenuation of normal adipose and glandular tissue, and to measure the effect of formalin fixation, a major uncertainty in published data. A total of 27 tumour specimens, seven fibro-glandular tissue specimens, and 15 adipose tissue specimens were included. Spectral (energy-resolved) images of the samples were acquired and the image signal was mapped to equivalent thicknesses of two known reference materials, from which x-ray attenuation as a function of energy can be derived. The spread in attenuation between samples was relatively large, partly because of natural variation. The variation of malignant and glandular tissue was similar, whereas that of adipose tissue was lower. Formalin fixation slightly altered the attenuation of malignant and glandular tissue, whereas the attenuation of adipose tissue was not significantly affected. The difference in attenuation between fresh tumour tissue and cyst fluid was smaller than has previously been measured for fixed tissue, but the difference was still significant and discrimination of these two tissue types is still possible. The difference between glandular and malignant tissue was close-to significant; it is reasonable to expect a significant difference with a larger set of samples. [cropped]
Measurement of breast-tissue x-ray attenuation by spectral mammography: solid lesions
Jan 07, 2021

Abstract:Knowledge of x-ray attenuation is essential for developing and evaluating x-ray imaging technologies. For instance, techniques to distinguish between cysts and solid tumours at mammography screening would be highly desirable to reduce recalls, but the development requires knowledge of the x-ray attenuation for cysts and tumours. We have previously measured the attenuation of cyst fluid using photon-counting spectral mammography. Data on x-ray attenuation for solid breast lesions are available in the literature, but cover a relatively wide range, likely caused by natural spread between samples, random measurement errors, and different experimental conditions. In this study, we have adapted the previously developed spectral method to measure the linear attenuation of solid breast lesions. A total of 56 malignant and 5 benign lesions were included in the study. The samples were placed in a holder that allowed for thickness measurement. Spectral (energy-resolved) images of the samples were acquired and the image signal was mapped to equivalent thicknesses of two known reference materials, which can be used to derive the x-ray attenuation as a function of energy. The spread in equivalent material thicknesses was relatively large between samples, which is likely to be caused mainly by natural variation and only to a minor extent by random measurement errors and sample inhomogeneity. No significant difference in attenuation was found between benign and malignant solid lesions, or between different types of malignant lesions. The separation between cyst-fluid and tumour attenuation was, however, significant, which suggests it may be possible to distinguish cystic from solid breast lesions, and the results lay the groundwork for a clinical trial. [cropped]
 Add to Chrome
Add to Chrome Add to Firefox
Add to Firefox Add to Edge
Add to Edge